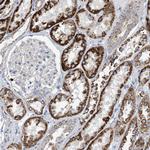
CLEC16A Antibody in Immunohistochemistry (Paraffin) (IHC (P))

Search
Invitrogen
CLEC16A Polyclonal Antibody
{{$productOrderCtrl.translations['antibody.pdp.commerceCard.promotion.promotions']}}
{{$productOrderCtrl.translations['antibody.pdp.commerceCard.promotion.viewpromo']}}
{{$productOrderCtrl.translations['antibody.pdp.commerceCard.promotion.promocode']}}: {{promo.promoCode}} {{promo.promoTitle}} {{promo.promoDescription}}. {{$productOrderCtrl.translations['antibody.pdp.commerceCard.promotion.learnmore']}}
产品信息
PA5-57408
种属反应
宿主/亚型
分类
类型
抗原
偶联物
形式
浓度
规格
纯化类型
保存液
内含物
保存条件
运输条件
RRID
产品详细信息
Immunogen sequence: VPYFSNLVWF IGSHVIELDD CVQTDEEHRN RGKLSDLVAE HLDHLHYLND ILIINCEFLN DVLTDHLLNR LFLPLYVYSL ENQDKGGERP KISLPVSLYL LSQVFL
Highest antigen sequence identity to the following orthologs: Mouse - 98%, Rat - 97%.
靶标信息
This gene encodes a member of the C-type lectin domain containing family. Single nucleotide polymorphisms in introns of this gene have been associated with diabetes mellitus, multiple sclerosis and rheumatoid arthritis. Multiple transcript variants encoding different isoforms have been found for this gene.
仅用于科研。不用于诊断过程。未经明确授权不得转售。
篇参考文献 (0)
生物信息学
蛋白别名: C-type lectin domain family 16 member A; MGC111457; Protein CLEC16A
基因别名: CLEC16A; Gop-1; KIAA0350
UniProt ID: (Human) Q2KHT3
Entrez Gene ID: (Human) 23274